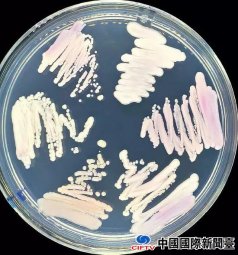

【环球网报道记者崔杰通王心怡】据美联社报道,当地时间4月19日,休斯顿一家著名的癌症中心驱逐了3名华裔科学家,理由是联邦当局认定这些人“参与了中国窃取美国研究成果的行动”。就在前几天,《纽约时报》披露美国联邦调查局(FBI)对多名中国学者搞“签证封锁”,引发多方对美国犯了“疑心症”的质疑。

美联社报道截图
报道称,MD安德森癌症中心总裁彼得·皮斯特斯告诉《休斯顿纪事报》,美国国家卫生研究院2018年曾致信该癌症中心,详述了五名员工之间的利益冲突和未报告的海外收入,并给了该中心30天的时间做出回应。
该中心向《休斯敦纪事报》提供了有关这些案件的内部文件,但科学家的名字有所改动。《休斯敦纪事报》表示,被驱逐的三个人都是华裔。其中两人在撤职前辞职,另一人对撤职一事提出质疑。
报道称,目前尚不清楚他们中任何一人是否会面临联邦指控或被驱逐出境。
美国联邦调查局发言人克里斯蒂娜·加尔扎20日在休斯敦表示,FBI“对是否存在调查既未证实也未否认。”
按皮斯托斯的说法,MD安德森癌症中心是世界排名第一的癌症中心。美联社报道称,该中心获得了美国国家卫生研究院1.48亿美元的资助。美联社称,《休斯敦纪事报》报道中并未说明这家癌症中心发现了何种盗窃知识产权证据。
《洛杉矶时报》引述美联社的报道称,一些华裔美国人说,这种行为镇压相当于种族脸谱化,会阻碍研究取得突破性进展。
“科学研究依赖于观念的自由流动,”总部位于纽约由有影响力的华裔美国人组成的百人会主席弗兰克·吴对美国媒体表示:“美国推进国家利益的最佳方式是欢迎人民,而不是基于一个人来自哪里的种族成见。”